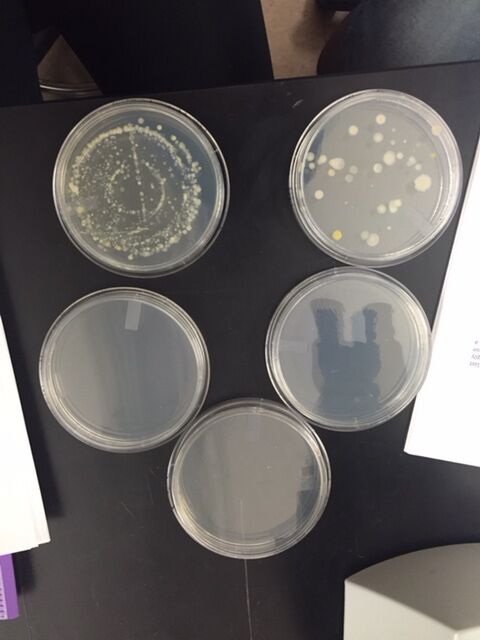

User:Student 65/Notebook/Biology 210 at AU
March 10, 2016 - Food Web
Purpose:
The purpose of this exercise was to use our knowledge of the transect we have analyzed for the past few weeks and identify the relationships between organisms by crafting a potential food web for the transect.
Materials and Methods:
Use data from prior experiments (Experiments I-V) to determine the relationships between the organisms observed. From the relationships and interactions, create a food web.
Data and Observations:
Figure 1: Food Web for organisms in Transect 1
Conclusions and Future Directions:
It is apparent that all of the organisms living in this transect are dependent on one another. In general, many of the smaller, more complex organisms are capable of sustaining life on their own, while the larger, more complex organisms rely on these smaller organisms for a source of food. This food web could be improved by getting into some of the specifics, such as which bacteria and fungi, what types of plants some of the vertebrates eat, etc.
--Emily J. Kinneston 23:52, 24 February 2016 (EST)
February 18, 2016 - Exercise VI: Embryology and Development
Purpose:
The purpose of this experiment is to determine the effect of sodium fluoride on zebrafish. Specifically to analyze its chemical effect on the development and viability. We hypothesized that the sodium fluoride will affect the size of the fish, the eye size, and effect the liver of the fish. By using a small dose of sodium fluoride, we hope that the effects are not too severe and kill the fish, instead we hope the effects are more mild and can be observed.
Materials and Methods:
Fill a 24 well plate, the control plate, with 2mL of deer park water. In a separate 24 well plate, the experimental plate, add 2mL of 7.5ppm (0.0075mg/mL) solution of NaF and water solution. In all 48 wells, place one fertilized zebrafish embryo. Observe the zebrafish on days 2, 5, 6 and 7. Make sure to clean the solution by pipetting the dirty solution out and replacing with fresh solution. On the fifth day, begin feeding the fish as they grow.
Data and Observations:
Figure 1: Control plate
Figure 2: Experimental plate
--Emily J. Kinneston 23:52, 24 February 2016 (EST)
February 25, 2016 - Exercise V Continued: 16s Sequence Analysis
Purpose:
The purpose of this experiment was to determine the species present from a bacterial sample collected from Transect 5. To do this, the 16S mRNA sequence will be run in BLAST ® and the results will be compared to the results from the gram stain and wet mount analysis.
Materials and Methods:
Find the sequence for the 16S mRNA and use BLAST ® technology to determine the species present.
Data and Observations:
Figure 1: Gel from Microbiology Lab
Raw Sequence:
CAATCCTGGCGGCGAGTGGCGAACGGGT GAGTAATACATCGGAACGTGCCCAATCGTGGGGGATAACGCAGCGAAAGCTGTGCTAATACCGCATACGATCTACGGATG AAAGCAGGGGATCGCAAGACCTTGCGCGAATGGAGCGGCCGATGGCAGATTAGGTAGTTGGTGAGGTAAAGGCTCACCAA GCCTTCGATCTGTAGCTGGTCTGAGAGGACGACCAGCCACACTGGGACTGAGACACGGCCCAGACTCCTACGGGAGGCAG CAGTGGGGAATTTTGGACAATGGGCGAAAGCCTGATCCAGCCATGCCGCGTGCAGGATGAAGGCCTTCGGGTTGTAAACT GCTTTTGTACGGAACGAAACGGCCTTTTCTAATAAAGAGGGCTAATGACGGTACCGTAAGAATAAGCACCGGCTAACTAC GTGCCAGCAGCCGCGGTAATACGTAGGGTGCAAGCGTTAATCGGAATTACTGGGCGTAAAGCGTGCGCAGGCGGTTATGT AAGACAGTTGTGAAATCCCCGGGCTCAACCTGGGAACTGCATCTGTGACTGCATAGCTAGAGTACGGTAGAGGGGGATGG AATTCCGCGTGTAGCANTGNAATGCGTAGATATGCGGAGGAACACCGATGGCGAANGCAATCCCCTGGACCTGTACTGAC GCTCATGCACGAAAGCGTGGGGAGCAAACAGGATTAGATACCCTGGTAGTCCACGCCCTAAACGATGTCAACTGGTTGTT GGGTCTTCACTGACTCA
BLAST ® Results:
Variovorax paradoxes - this result was 99% accurate.
Conclusions and Future Directions:
Variovorax paradoxes is a Gram-negative, rod-shaped aerobic bacterium from the genus Variovorax. Both of our bacterial gram-stains were negative and rod-shaped just like the v. paradoxes. This bacteria plays an important role in biodegradative processes in nature and can also promote plant growth (Jamieson, Pehl, Gregory, & Orwin, 2009).
References:
Jamieson, W. D., Pehl, M. J., Gregory, G. A., & Orwin, P. M. (2009). Coordinated surface activities in Variovorax paradoxus EPS. BMC Microbiology, 9(1), 1–18. http://doi.org/10.1186/1471-2180-9-124
--Emily J. Kinneston 21:39, 1 March 2016 (EST)
February 11, 2016 - Exercise V: Invertebrates and Vertebrates
Purpose:
To analyze the Berlese Funnel created last class and use a dichotomous key to identify and characterize the invertebrates found in our transect. We hypothesize that we will find a variety of different invertebrates in our transect.
Materials and Methods:
Break down the Berlese Funnel (carefully) and pour the top 10-15 mL of the ethanol solution into a petri dish. Pour the remaining liquid into a second petri dish. Using a dissecting microscope, analyze the two dishes and identify all of the invertebrates that can be found (at least five). Determine the organism name using the dichotomous key and record all observations on the organism in a table (include length, number present, and a description).
Observations and Data:
Table 1: Transect Invertebrates
Figure 1: Organism 1 - Springtail
Figure 2: Organism 2 - Biting Lice
Figure 3: Organism 3 - Deer Tick
Figure 4: Organism 4 - Termite
Figure 5: Organism 5 - Black Ant
Figure 6: Transect Vertebrates
Conclusions and Future Directions:
Our hypotheses was wrong in that we had a variety of different organisms in our transect; however, these species all had the same phylum: Arthropoda, and there were only two different classes: insecta and Arachnida. Interestingly enough, the largest organism was found in the top solution. The three smallest organisms were found in the bottom solution.
--Emily J. Kinneston 12:48, 19 February 2016 (EST)
February 4, 2016 - Exercise IV: Plantae and Fungi
Purpose:
The purpose of this experiment was to analyze (identify the vascularization, specialized structures and mechanisms of reproduction) the various plants found in our transect. We also set up a Bernese Funnel, which will be used to collect the Invertebrates that will be analyzed in the next lab.
Materials and Methods:
Collect five different plant samples from the transect and place in Ziploc bag (include any seeds, pine cones or flowers). Characterize the vascularization of each plant, once in the lab, and measure the height and cross section from each. Observe the cross sections under a dissection microscope. Disect the seeds from the transect and identify if they are dicot or monocot. In a separate Ziploc bag place a leaf litter sample. Examine the leaf litter and record the shape, cluster arrangement, and size of the leaves. Prepare a Berlese funnel by adding 25mL of 50:50 ethanol/water solutions to a 50mL conical tube. Place a screen into the bottom of a funnel and put the leaf litter on top. Put the funnel onto a ring stand with the conical tube attached to the bottom of the funnel. Place under a 40-watt lamp, cover with foil and let sit until next lab period. Observe bread mold and other fungi under the direction microscope.
Observations and Data:
Figure 1: An ariel view of the five plants from our transect: Plant 1 (left), Plant 5 (left of plant 1), Plant 3 (bottom), Plant 2 (top), Plant 4 (right)
Figure 2: Plant number one from the transect shown under the light microscope (top) and dissection microscope (bottom)
Figure 3: Plant number two from the transect
Figure 4: Plant number three from the transect
Figure 5: Plant number four from the transect
Figure 6: Plant number five from the transect
Table 1: Characteristics of Plants Collected from the Transect
Transect Sample Plants Location in Transect Description (size and shape) Vascularization Specialized Structures Mechanisms of Reproduction
- 1 On ground under light, left of the grass Light brown, dry, speckled outside; width: 5mm, length: 38mm Ring of vascular bundles (xylem and phloem ring) NA Dicot
- 2 In the back of the transect, under one of the small tree/ bush structure Jagged edges, green color; width: 13mm, length: 45mm Vascular bundles Stomata and epidermis Dicot
- 3 Located with the grass Small, light green leaves, jagged edges, oval in shape; width: 7mm, lenth:10mm Vascular bundles Stomata Dicot
- 4 A foot from the sidewalk Long grass, dark green; width: 5mm, lenth: 141mm Parallel veins Stomata Monocot
- 5 Far corner of transect (blown from another transect?) Pine needle, green in color, glossy; width: 1mm, length:10mm Parallel veins Somata Monocot
Figure 7: Seed found in our transect determined to be dicot
Figure 8: Bread mold under dissecting microscope
Figure 9: Mushroom observed under dissecting microscope
Conclusions and Future Directions:
We observed three dicot plants and two monocot plants in our transect, which means that our transect is diverse. Our plants varied in vascularization with either a ring of bundles or parallel veins. The seed we found in our transect was classified as dicot due to the split in its structure. The black bread mold observed is considered fungi sporangia and the spores can be observed under the microscope (seen in Figure 8).
--Emily J. Kinneston 16:18, 16 February 2016 (EST)
January 28, 2016 - Exercise III: Microbiology and Identifying Bacteria
Purpose:
The purpose of this experiment was to identify the bacterial species in our transect through analyzing the motility, gram stain, colony morphology, and sequencing (PCR) of samples taken from the Hay Infusion Culture.
Materials and Methods:
Hay Culture Observations:
Observe the Hay Infusion Culture and the changes in appearance and smell. Observe the agar plates inoculated with the Hay Infusion Culture and record observations about the number of colonies, the shape of the colonies and the size of the colonies.
Wet Mount:
Prepare wet mount slides to determine the shape and motility of the organisms. To do this, sterilize a loop over flame of a bunsen burner and let cool. Scrape a tiny amount of growth from the agar plate. Mix with a drop of water on a slide and top with a cover slip. Observe this wet mount using both the 10X and 40X objective lenses. Complete this process with the two agar plates that had growth.
Gram Stain:
Prepare gram stain slides to further differentiate the microorganisms. To do this, sterilize a loop and scrap a tiny amount of growth and mix with water (like the first step to the wet mount procedure). Heat fix the slide by passing it over a bunsen burner. On the staining tray, cover the slide with crystal violet for one minute. Rinse with water and cover with iodine for one minute. Rinse with water and cover with safranin stain for 30 seconds. Rinse and blot excess water with kimwipe. Observe stain on 10X, 40X and 100X objectives.
PCR Set Up:
Label 2 PCR tubes (transect number, colony identifies, etc.). Add 20 μL of primer/water mixture into PCR tube and mix until the PCR bead is completely dissolved. Pick up small amount of bacterial colony from agar plate with sterile toothpick and submerge into PCR tube, twisting the toothpick to get colony into solution. Cap the tube and place into the PCR machine overnight. Repeat for both successful agar plates.
Observations and Data:
Hay Infusion Culture Observation: The smell of the culture is milder than last week. It smells mostly like dirt. The water level has decreased from the previous week and the film on top of the surface is less distinct.
Figure 1: Nutrient Agar Plates. Top Right: 10^-3 dilution of Hay Infusion Culture. Bottom Right: 10^-5 dilution of Hay Infusion Culture. Top Left: 10^-7 dilution and Bottom Right: 10^-9 dilution. Middle: 10^-3 dilution on nutrient + tet plate.
Colonies didn't form on the 10^-7 and 10^-9 dilutions of the Hay Infusion Culture on nutrient agar plates. We were only able to test one dilution (the 10^-3 dilution) with the nutrient and tetracycline plate due to a lack of materials. This plate didn't observe any growth.
Table 1: 100-fold Serial Dilutions Results
Dilution_Agar type_# Colonies on plate_Conversion factor_Colonies/ml
10^-3____nutrient__________880______________x 10^3________ 880000
10^-5____nutrient___________35______________x 10^5_________3500000
Figure 2: Wet mount of 10^-3 serial dilution of Hay Infusion Culture grown on nutrient agar
Figure 3: Wet mount of 10^-5 serial dilution of Hay Infusion Culture grown on nutrient agar
Figure 4: Gram stain of 10^-3 serial dilution of Hay Infusion Culture grown on nutrient agar
Figure 5: Gram stain of 10^-5 serial dilution of Hay Infusion Culture grown on nutrient agar
Table 2: Bacteria Characterization
Colony Label__Plate Type__Colony Description (diameter, color, shape, texture)__Cell Description (motility, shape, arrangement)__Gram + or Gram –
10^-3__________nutrient_______violet and pink, 0.5μm, smooth_________________________rod-shaped, non motile______________Gram + and Gram -
10^-5__________nutrient__________pink, 0.5μm, smooth________________________________sphere, non motile_________________Gram -
Conclusions and Future Directions:
Due to the lack of tetracycline plates available for use, we were unable to fully analyze our transect and the bacteria within it. Especially since the tetracycline plate didn't have any growth. Tetracycline is a antibiotic that has also been used to treat heart and brain conditions (ATTAR, 2009). Tetracyclines are bacteriostatic, that is, they prevent the synthesis of bacterial protein synthesis at the ribosomal level (Attar, 2009). With this in mind, we would expect the tetracycline nutrient agar plates to have a reduced number of colonies if the specific bacteria could be treated with tetracycline, which technically we did in our experiment (we observed zero colonies). However, since we only had one plate to analyze, our results were still inconclusive. The observed wet mounts and gram stain slides proved that the bacterial colonies that did grow were different because they differed in shape, size, and gram stain results.
References:
ATTAR, S. M. (2009). Tetracyclines: what a rheumatologist needs to know?. International Journal Of Rheumatic Diseases, 12(2), 84-89. doi:10.1111/j.1756-185X.2009.01389.x
--Emily J. Kinneston 22:13, 15 February 2016 (EST)
January 21, 2016 - Exercise II: Identifying Algae and Protists
Purpose:
The purpose of this experiment was to observe unicellular eukaryotic organisms in order to further our understanding of them. We will practice important techniques used to identify protists and algae. Specifically, a dichotomous key will be used to characterize and identify the unknown organisms from our Hay Infusion. Preparation for the next lab.
Materials and Methods:
Hay Infusion Culture Observations - Observe the culture created last class and record all observations (i.e. smell, appearance). Make two wet mounts from the culture and observe under the microscope and determine which protists and/or algae are present using the dichotomous key. Record all observations, including size, motility, are they photosynthesizing, etc.
Serial Dilution Preparations - Mix Hay Infusion Culture with swirling technique. Combine 100μL of the culture with 10mLs of broth in a tube labeled 10-2. Combine 100μL of the 10-2 dilution with 10mLs broth in a tube labeled 10-4. Combine 100μL of the 10-4 dilution with 10mLs broth in a tube labeled 10-6. Combine 100μL of the 10-6 dilution with 10mLs broth in a tube labeled 10-8. Plate 100μL of each serial dilution on properly labeled nutrient agar plates. Plate 100μL of each serial dilution on properly labeled nutrient agar plates plus tetracycline.
Figure 1: Diagram of serial dilution procedure
Data and Observations:
The Hay Infusion Culture smelled rancid. It smelled like a combination of mold/mildew, dirt and feces. It appeared to be foggy, brown in color with a few strands of green grass with an opaque mold on the tip, and a yellow/brown film along the rim and on the top of the water, which could possibly be mold.
Figure 2: Hay Infusion Culture with 3 niches (top: moldy film, middle: foggy liquid, bottom: dirty, leafy)
Niche 1 (top layer) Organisms
Figure 3: Organism 1 - Stramenopila algae - golden brown in color, 100μm, nonmotile
Figure 4: Organism 2 - Pelomyxa - clear, small, approx. 30μm, motile, slow moving, many small nuclei
Figure 5: Organism 3 - Chlamydomonas - round/ circular, small, approx. 25μm, unicellular, nonmotile
Niche 2 (middle layer) Organisms
Figure 6: Organism 4 - Euglena - green in color, single motile cell, approx. 10μm, one flagella, elongated
Figure 7: Organism 5 - Pandorina - pinkish membrane, green inside, clustered/touching, 25μm-40μm, colonial, uniform, single nucleus (pinkish purple in color)
Figure 8: Organism 6 - Volvox algae - spherical in shape, colony, green in color, non-motile, floating
Conclusions and Future Directions:
It can be concluded that our transect contains multiple protist and algae species. The serial dilutions prepared at the end of this experiment will allow us to further analyze our transect by allowing us to identify the bacterial species in our transect.
--Emily J. Kinneston 12:10, 10 February 2016 (EST)
January 14, 2016 - Exercise I: Examining Biological Life at AU
Purpose:
The purpose of this experiment was to observe a specific 20 by 20 meter transect of land here at American University with which we will later characterize the different forms of life inhabiting that specific transect (the protists, bacteria, plants, invertebrates and animals). A hay infusion culture was made using a sample of the soil from the transect and will be used to analyze the protists and invertebrates from the specific niche. Our group hypothesized that our hay infusion culture will yield a variety of different organism, specifically protists and algae.
Materials and Methods:
For transect - Identify the transect (marked by four popsicle sticks with the number 1 on them). Record all observations of the transect, including its topography and location. Take a photo of the transect and draw an ariel-view diagram of the transect, making sure to note both abiotic and biotic features. Collect a sample from the transect to be used in the hay infusion.
For Hay Infusion - Mix 10-12 grams of collected sample, 500 mLs deerpark watered 0.1 gram dried milk in a closed, labeled jar for 10 seconds. Remove lid to jar and let sample sit in safe place in lab until next lab period.
Data and Observations:
The transect was located to the North East of Hurst Hall on the other side of the cross walk. It is a flat section of land with a sidewalk on one side and a cement fence on the other. The transect contains a variety of different biotic and abiotic components and some manmade components (light posts, sprinklers, etc.). Some of the biotic components observed include: a large tree, smaller trees and bushes, grass, organisms living in the soil, and potential animals living in the environment. The abiotic components of the transect included: soil, the sprinklers (a source of water), light (from the light post), and litter (a straw and cigarette).
Figure 1: Photograph of the transect from the North East side (facing South West)
Figure 2: An ariel diagram of the transect with abiotic and biotic factors labeled
Conclusions and Future Directions:
After observing the transect, it can be concluded that there is a variety of different abiotic and biotic components to our transect. The next step is to analyze what niches are present in our ecosystem. The hay infusion will be observed in the next class, with which we hope to gain a better understanding of our transect.
--Emily J. Kinneston 17:28, 2 February 2016 (EST)